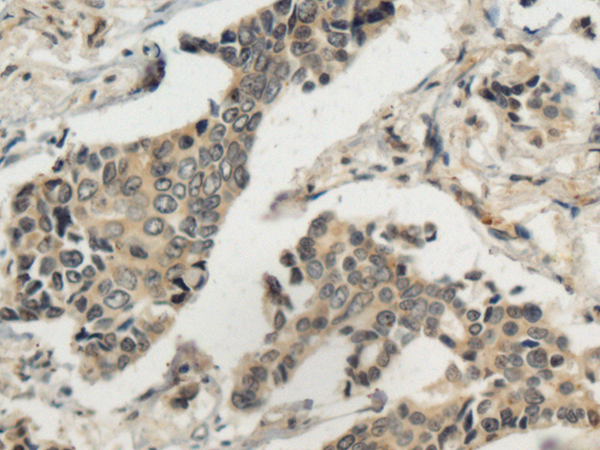
一抗

中文名稱: 兔抗MASP1多克隆抗體
英文名稱: Anti-MASP1 rabbit polyclonal antibody
別 名: 3MC1; MAP1; MASP; RaRF; CRARF; MASP3; MAp44; PRSS5; CRARF1
抗 原: MASP1
儲(chǔ) 存: 冷凍(-20℃)
宿 主: Rabbit
相關(guān)類別: 一抗
反應(yīng)種屬: Human
標(biāo) 記 物: Unconjugate
克隆類型: rabbit polyclonal
技術(shù)規(guī)格
|
Background: |
This gene encodes a serine protease that functions as a component of the lectin pathway of complement activation. The complement pathway plays an essential role in the innate and adaptive immune response. The encoded protein is synthesized as a zymogen and is activated when it complexes with the pathogen recognition molecules of lectin pathway, the mannose-binding lectin and the ficolins. This protein is not directly involved in complement activation but may play a role as an amplifier of complement activation by cleaving complement C2 or by activating another complement serine protease, MASP-2. The encoded protein is also able to cleave fibrinogen and factor XIII and may may be involved in coagulation. A splice variant of this gene which lacks the serine protease domain functions as an inhibitor of the complement pathway. Alternate splicing results in multiple transcript variants. |
|
Applications: |
ELISA, WB, IHC |
|
Name of antibody: |
MASP1 |
|
Immunogen: |
Fusion protein of human MASP1 |
|
Full name: |
mannan binding lectin serine peptidase 1 |
|
Synonyms: |
3MC1; MAP1; MASP; RaRF; CRARF; MASP3; MAp44; PRSS5; CRARF1 |
|
SwissProt: |
P48740 |
|
ELISA Recommended dilution: |
5000-10000 |
|
IHC positive control: |
Human prostate cancer and Human breast cancer |
|
IHC Recommend dilution: |
100-300 |
|
WB Predicted band size: |
79 kDa |
|
WB Positive control: |
Human heart tissue and Hela cell lysates |
|
WB Recommended dilution: |
500-2000 |



 購(gòu)物車
購(gòu)物車 幫助
幫助
 021-54845833/15800441009
021-54845833/15800441009